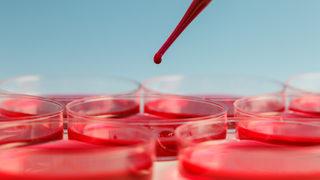
Demir eksikliği yaşamsal öneme sahip! Dünya nuüfusunun yüzde 30'u...

Demir Eksikliği Haberleri Ve Son Dakika Demir Eksikliği Haberleri
Demir eksikliği haberleri sayfası, beslenme ve sağlık konularına ilgi duyan herkes için önemli bir bilgi kaynağıdır. Son dönemlerde artan sağlık bilinci ile birlikte, demir eksikliği ile ilgili gelişmeler de yakından takip edilmektedir. Özellikle, demir eksikliği son dakika haberleri, bu konuda yenilikleri ve güncel bilgiye ulaşmayı sağlamak adına kritik bir rol oynamaktadır.
Güncel demir eksikliği haberleri, bu besin maddesinin vücut üzerindeki etkileri hakkında bilinçlenmemize yardımcı olurken, yeterli demir alımı için hangi kaynakların tüketilmesi gerektiği konusunda da ipuçları sunmaktadır. Hem bireylerin sağlık durumunu iyileştirmek hem de toplumsal farkındalığı artırmak amacıyla sunulan bu haberler, alanında uzman kişiler tarafından kaleme alınmakta ve okuyuculara en doğru bilgiye ulaşma imkanı sağlamaktadır.

Haber Gönder
Haber Gönder